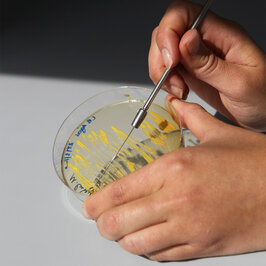

Frist verlängert: Bewirb dich jetzt für den Start im Sommersemester!
Gestalte die Zukunft der Medizin
Du willst verstehen wie der menschliche Körper funktioniert – vom Großen bis zu den kleinsten Molekülen? Welche Prozesse führen zur Entstehung von Krankheiten? Und wie lassen sich diese erkennen, analysieren und behandeln?
Hier lernst du nicht nur, wie Gesundheit und Krankheit auf molekularer und zellulärer Ebene zusammenspielen, sondern auch, wie moderne Diagnostik funktioniert.
Ein besonderer Schwerpunkt liegt auf der praxisnahen Ausbildung: In Laborpraktika erlernst du Techniken aus Molekularbiologie, Zellbiologie und Mikrobiologie. Neben biologischen und medizinischen Inhalten wartet eine spannende Technikkomponente auf dich: Bildgebung, Bioinformatik und Datenanalyse machen dich fit für die Zukunft.
Dank der bilingualen Ausrichtung bist du bestens vorbereitet für eine Karriere in Wissenschaft und Industrie.
Details zum Studiengang
Studieninhalte und Aufbau
Die moderne Biomedizin leistet einen wichtigen Beitrag, um die großen Herausforderungen des 21. Jahrhunderts zur bewältigen. Deshalb studierst du bei uns im Studiengang aktuelle Themen – und zwar fächerübergreifend. Du lernst neben klassischen Naturwissenschaften und Molekularbiologie auch anwendungsbezogene Inhalte aus Medizin, Labordiagnostik und der Medizintechnik. Zunehmend relevant ist die Analyse großer Datenmengen, auch darin bilden wir dich aus. Damit kannst du in vielen verschiedenen Berufsfeldern durchstarten. Weil sowohl im Arbeitsmarkt als auch in der Forschung ständig Link öffnet sich im gleichen Fenster:neue Themen und Techniken im Mittelpunkt stehen, optimieren wir unsere Studieninhalte immer wieder, damit du fachlich auf dem neuesten Stand bist!
Du hast Fragen zu MTZ? Datei herunterladen:Hier findest du unsere FAQ
Voraussetzungen
Besondere Vorkenntnisse werden nicht vorausgesetzt. Du solltest aber Interesse an Naturwissenschaften (Biologie, Chemie, Physik und Mathematik) mitbringen und medizinische Fragestellungen spannend finden, zum Beispiel "wie entstehen Krankheiten?" oder "wie funktioniert der Körper auf molekularer oder zellulärer Ebene?".
Das Sprachniveau in Deutsch muss mindestens dem TestDaF TDN4, dem Zertifikat 'Deutsch C1 Hochschule', der Prüfung DSH-2 oder einer vergleichbaren Qualifikation entsprechen.
MTZ ganz konkret
Das zeichnet uns aus
Hoher Praxisbezug durch viele Laborpraktika in kleinen Gruppen, das praktische Studiensemester und die Bachelorthesis (beides vorzugsweise in einer Forschungseinrichtung oder im Unternehmen).
Interdisziplinarität: Du lernst nicht nur humanbiologische / medizinische Inhalte, sondern auch wissenschaftliches Arbeiten, Qualitätsmanagement, BWL. Inhalte, die dir bei der Karriere in Wissenschaft, Industrie und angewandter Forschung helfen. Zudem bieten dir die breitgefächerten Inhalte das Fundament für viele weiterführende Studiengänge.
Flexibel studieren: Wenn du möchtest, kannst du drei von sieben Semestern woanders verbringen. Wir unterstützen dich bestmöglich bei der Suche nach einem Platz für dein Praktisches Studiensemester, einem Auslandssemester oder der Thesis in einem Unternehmen oder einer Forschungseinrichtung.
Hoher Forschungsbezug: Wir sind eine der forschungsstärksten Hochschulen und die forschungsstärkste Fakultät an der HFU. Davon profitierst du durch gut ausgestattete Labore und eine mögliche Mitarbeit an Projekten.
Bilingualer Studiengang mit optionalem bilingualem Abschluss. Mehr findest Du weiter unten im Bereich: Besonderheiten.
Wenn Du bei uns studieren möchtest, stehen die Chancen sehr gut. Link öffnet sich im gleichen Fenster:Bewirb dich, wir freuen uns auf dich!
Und das steckt drin
Semesterbeitrag
Achtung: Ohne Zahlung des Semesterbeitrags ist keine Immatrikulation möglich!
Alle Studierenden der Hochschule Furtwangen bezahlen pro Semester einen Semesterbeitrag in Höhe von 176 Euro.
Besonderheiten
Wir sind International und bilingual aufgestellt
Englischsprachige Fächer sind Pflichtbestandteil des Curriculums. Diese findest du vorwiegend im Hauptstudium. Um den Einstieg zu erleichtern finden in den ersten beiden Studiensemester verpflichtende Sprachkurse statt, in die du (nach einem Sprachtest) eingestuft wirst. Am Ende des Studiums wirst du mindestens das Englisch Level B 2.2. erreicht haben.
Bilingualer Abschluss
Der bilinguale Abschluss ist optional. Um diesen zu erreichen, musst du von den 210 ECTS-Leistungspunkten des Bachelor-Studienganges mehr als mind. 61 ECTS-Leistungspunkte in Englisch absolvieren. Zudem musst du durch einen unabhängigen Sprachtest, den Nachweis mindestens des Levels C1 Englisch erbringen.
Während des Studiums hast du die Möglichkeit, ECTS in der Zielsprache Englisch zu erwerben, z.B. durch:
Englischsprachige Veranstaltungen an der HFU (auch Wahlfächer).
Link öffnet sich im gleichen Fenster:Praktisches Studiensemester im Ausland: Hauptkommunikationssprache der Praxissemesterstelle muss Englisch sein.
Link öffnet sich im gleichen Fenster:Auslandsstudiensemester mit Unterrichtssprache Englisch
Thesisarbeit: Ausarbeitung und Vortrag müssen auf Englisch sein. Als Hauptkommunikationssprache in der Arbeitsgruppe/ Einrichtung wird Englisch empfohlen.
Studierende, die im Hauptstudium mindestens 61 ECTS in Englisch absolviert haben, können am Ende ihres Studiums bei der Studiendekanin/ dem Studiendekan den Bilingualen Abschluss beantragen.
Erfahrungsberichte zum Auslandssemester
Deine Karriereaussichten
Der zweite Link öffnet sich im gleichen Fenster:MTZ-Alumni-Nachmittag am 23.05.2025 bot wertvolle Einblicke in unterschiedliche Karrierewege und zeigte die vielfältigen beruflichen Perspektiven nach dem Studium auf.
Erfolgsgeschichten unserer Alumni
Was du mit einem MTZ-STudium alles erreichen kannst, siehst du besonders gut an den Werdegängen unserer Alumni. Hier haben wir dir einige Beispiele zusammengestellt.
Berufsfelder
Wirtschaft und Industrie, Forschung und Entwicklung
- Grundlagenforschung, angewandte Forschung
- Qualitätsmanagement / Qualitätssicherung
- Produktentwicklung / Produktmanagement
Laboreinrichtungen, Forschung und Entwicklung
- Grundlagenforschung, Promotion
- Entwicklung und Durchführung wissenschaftlicher und allgemeiner Evaluationen
Kliniken und Medizinische Versorgungszentren
- Mitarbeit in der Diagnostik
- Qualitätsmanagement, Hygiene
- Medizintechnik, Labortechnik, Umweltschutz, Umweltmedizin
- Kardiotechnik (nach entsprechender Spezialisierung)
- Mitarbeit am Design und der Durchführung klinischer Studien
Behörden mit den Schwerpunkten Sicherheit, Umwelt und Hygiene
- Qualitätsmanagement
- Hygienemanagement
- Infektionsschutz
FAQ
Welche Vorkenntnisse für das Studium Molekulare und Technische Medizin werden vorausgesetzt?
Besondere Vorkenntnisse werden nicht vorausgesetzt, du solltest dich aber für die Naturwissenschaften (Biologie, Chemie, Physik und Mathematik) und medizinische Fragestellungen interessieren (bspw. Anatomie, Physiologie).
Wie hoch ist der Anteil an mathematisch-naturwissenschaftlichen und technischen Fächern im Studium?
In den ersten beiden Semestern (dem Grundstudium) ist der Anteil an Chemie, Mathematik, Physik und Technik mit insgesamt ca. 50 Prozent relativ hoch. Diese Grundlagen sind unabdingbar für ein Studium im naturwissenschaftlich-technischen Bereich. Im Hauptstudium werden vor allem biologische und medizinische Grundlagen anwendungsbezogen vertieft.
Ich hatte relativ wenig Mathematik/ Physik/ Chemie in der Schule. Wie sind meine Chancen in den entsprechenden Fächern einzuschätzen?
Eine pauschale Aussage ist nicht möglich. Der Erfolg in diesen Fächern hängt stark vom persönlichen Engagement und deinen (Vor-) Kenntnissen ab. Bei Bedarf werden Tutorien und Übungen in den entsprechenden Fächern angeboten. Auch besteht die Möglichkeit zur Vermittlung privater Nachhilfe. Wenn du bei uns zum Wintersemester startest, bieten wir oft sogenannte „Brückenkurse“ in Mathematik und Chemie an. Dort werden schulische Inhalte wiederholt. Solltest du diese Fächer z.B. nicht bis zum Ende der Schulzeit belegt haben oder du weißt, dass du hier noch Defizite hast, empfehlen wir die Teilnahme an der Brückenkursen. Diese sind freiwillig und kostenfrei. Die Info zu den Brückenkursen bekommst du nach dem Zulassungsbescheid.
Ist der Studienbeginn im Sommer- und im Wintersemester möglich?
Ja, du kannst das Studium der Molekularen und Technischen Medizin sowohl im Sommer- als auch im Wintersemester beginnen.
Wo finde ich Informationen zum Bewerbungs- und Zulassungsverfahren?
Link öffnet sich im gleichen Fenster:Hier erfährst du, wie du dich für MTZ bewerben kannst.
Wo liegt der Numerus Clausus?
Einen generellen Numerus Clausus gibt es nicht. Der Schnitt, bei dem noch Bewerbende zum Studium zugelassen wurden lag bisher zwischen 1,9 und 3,0, dieser ist abhängig von der Anzahl und Qualifizierung der Bewerbenden. Übersteigt die Zahl der Bewerbungen die Anzahl der freien Studienplätze, so werden nach Abzug der Vorabquoten die verfügbaren Studienplätze zu 90 % über ein hochschuleigenes Auswahlverfahren und zu 10 % über Wartezeit vergeben. In den letzten Semestern gab es keinen NC, das heißt es wurden alle Bewerbenden zugelassen.
Gibt es eine Fachschaft?
Ja, du erreichst die Fachschaft der Fakultät III über Instagram (fachschaft.fakultaet3) oder per Mail: fa3-fach@hs-furtwangen.de
Kann ich Leistungen aus anderen Studiengängen oder von beruflich erworbenen Kenntnissen anerkennen lassen?
Ja, unter bestimmten Voraussetzungen und nach Prüfung durch den Studiendekan. Genaueres erfährst du bei Studienbeginn.
Ist ein Quereinstieg möglich?
Ja, ein Quereinstieg in den Studiengang ist möglich, vorausgesetzt das Wunschsemester verfügt noch über freie Plätze. In deiner Bewerbung kannst du das gewünschte Einstiegssemester angeben. Im Einzelverfahren wird geprüft, ob der Antrag genehmigt wird. Genaueres dazu kannst du im Merkblatt zum Zulassungsantrag nachlesen. Wenn du unsicher bist, empfehlen wir dir einen Einstieg ins erste Semester, gegebenenfalls kannst du dir dann Veranstaltungen anrechnen lassen.
Gibt es einen passenden Master-Kurs?
Ja, an unserem Standort Schwenningen haben wir die beiden Masterstudiengängen „Precision Medicine Diagnostic (M.Sc.)“ und „Technical Physician (M.Sc.)". Diese Angebote kannst du direkt nach dem Bachelor-Abschluss oder nach einiger Zeit in der Berufstätigkeit für einen höher qualifizierenden Abschluss besuchen. Die Masterstudiengänge starten jährlich zum Wintersemester. Die meisten unserer Absolvierenden schließen ein Masterstudium an, vorwiegend in den Bereichen Biomedizin oder Molekulare Medizin (Stand Alumniumfrage 2025).
Neuigkeiten der Fakultät
Veranstaltungen und Events
Weitere Veranstaltungen und EventsDeine Kontaktpersonen
Wir beraten dich gerne zum Studiengang MTZ!

Angewandte Biologie (B.Sc.) (ANB)
Molekulare und Technische Medizin (B.Sc.) (MTZ) /
Physician Assistant (B.Sc.) (PA)
Precision Medicine Diagnostics (M.Sc.) (PMD)

…Oder du wendest dich an unsere Link öffnet sich im gleichen Fenster:Zentrale Studienberatung!